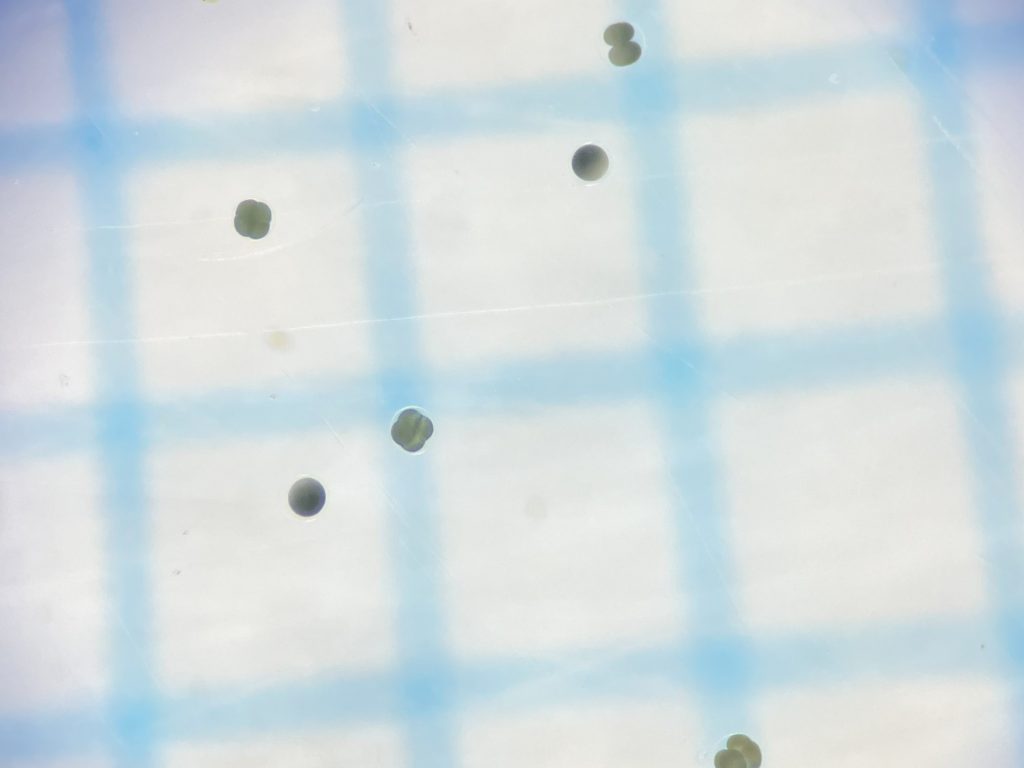

2025.10.23 無脊椎動物
命のドラマ
夏の厳しい暑さが和らぎ、ようやく涼しい日がちらほら出てきましたね。
タッチタンクでは様々な命が誕生しています。
まずはこちらをご覧ください↓
イシダタミという巻貝の仲間の放精放卵の様子です!
実は以前、謎の沈殿物が岩のくぼみに溜まっていたことがあり、何かわからずモヤモヤしていました。

放卵放精の様子を見て、その正体がイシダタミの卵だったことがわかり、謎が解けて感動しました!
顕微鏡で見てみると、卵はきれいな緑色でした。
(背景は1mm方眼紙です)
受精卵が分割し始めている様子もみてとれます。



受精卵はみるみる分割していき、幼生へと成長する様子も確認することができました!
イシダタミだけではありません。
次にご紹介するのは、石に空いた穴の中や石と石の隙間などに隠れて暮らす魚
「ナベカ」です。
こちらをご覧ください↓
オスが暮らす穴にメスが入り、卵を産み付け、オスは精子をふりかけていきます。
その後オスが卵を守り、1週間ほどたつと、孵化した仔魚を口にくわえて外に吐き出します!
次の写真は水槽の壁際を上から覗き込むようにして撮ったものです。
壁に注目すると…🔎

壁際に見える黒い点々!これらはすべて、全長約3mmのナベカの赤ちゃんです!
(壁の目盛りは1目盛り1cmです)
多い時では1回に20~30匹見つかることもあります。
拡大した姿がこちら↓

吐き出された先には仔魚を狙って他の魚が待ち構えており、仔魚が食べられてしまうこともしばしば…。
自然界は波や潮の満ち引きもあり、天敵も多く、もっと過酷な環境なはずです。
生き残ることができるのはほんの一握りと考えると、大人の個体は、たくさんの卵の中から多くの試練を乗り越え成長した、選ばれしものたちなのだなぁと、そのたくましさに心打たれます。
一見すると地味な水槽ですが、ここに暮らす生き物たちの命のドラマが日々繰り広げられています!
立ち寄った際にはぜひ足を止めて、彼らの暮らしぶりを覗いてみてはいかがでしょうか?
学習交流課 須原












